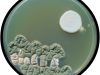

Fungi and bacteria on agar.
-
10-NZ UV
http://www.microbialart.com/wp-content/uploads/bfi_thumb/10-NZ-UV-31mp0467zplm9dhdsqwowa.jpg
-
20-Aspergillus-Zen-garden
http://www.microbialart.com/wp-content/uploads/bfi_thumb/20-Aspergillus-Zen-garden-31mp076s6qe4yjeb1jcfey.jpg
-
19-Turtles
http://www.microbialart.com/wp-content/uploads/bfi_thumb/19-Turtles-31mp06xqi5brefwk9sz47e.jpg
-
18-Rough Skin
http://www.microbialart.com/wp-content/uploads/bfi_thumb/18-Rough-Skin-31mp06t7nuskme5ovxsglm.jpg
-
17-Field of Yellow
http://www.microbialart.com/wp-content/uploads/bfi_thumb/17-Field-of-Yellow-31mp06ootk9duceti2lszu.jpg
-
16-Field of Green
http://www.microbialart.com/wp-content/uploads/bfi_thumb/16-Field-of-Green-31mp06k5z9q72any47f5e2.jpg
-
15-fluff
http://www.microbialart.com/wp-content/uploads/bfi_thumb/15-fluff-31mp06fn4z70a8x2qc8hsa.jpg
-
15-Aspergillus
http://www.microbialart.com/wp-content/uploads/bfi_thumb/15-Aspergillus-31mp066lge4mq5fbylv6kq.jpg
-
14-Verticillium RB
http://www.microbialart.com/wp-content/uploads/bfi_thumb/14-Verticillium-RB-31mp0622m3lfy3ogkqoiyy.jpg
-
14-sign
http://www.microbialart.com/wp-content/uploads/bfi_thumb/14-sign-31mp05t0xij2e06pt0b7re.jpg
-
13-self
http://www.microbialart.com/wp-content/uploads/bfi_thumb/13-self-31mp05jz8xgotwoz19xwju.jpg
-
13-Acremonium
http://www.microbialart.com/wp-content/uploads/bfi_thumb/13-Acremonium-31mp05axkceb9t789jklca.jpg
-
12-plates_assorted
http://www.microbialart.com/wp-content/uploads/bfi_thumb/12-plates_assorted-31mp051vvrbxppphht7a4q.jpg
-
12-heart
http://www.microbialart.com/wp-content/uploads/bfi_thumb/12-heart-31mp04su769k5m7qq2tyx6.jpg
-
11-Hook
http://www.microbialart.com/wp-content/uploads/bfi_thumb/11-Hook-31mp04jsil76lipzycgnpm.jpg
-
11-frog
http://www.microbialart.com/wp-content/uploads/bfi_thumb/11-frog-31mp04f9oanztgz4kha03u.jpg
-
01-Aesculapius_staff
http://www.microbialart.com/wp-content/uploads/bfi_thumb/01-Aesculapius_staff-31mozyrpt4oiradw8hyhvu.jpg
-
10-moon
http://www.microbialart.com/wp-content/uploads/bfi_thumb/10-moon-31mp041p5f2fhbqievq1ai.jpg
-
09-NZ Ps
http://www.microbialart.com/wp-content/uploads/bfi_thumb/09-NZ-Ps-31mp03sngu01x88rn5cq2y.jpg
-
09-mushroom
http://www.microbialart.com/wp-content/uploads/bfi_thumb/09-mushroom-31mp03o4mjgv56hw9a62h6.jpg
-
08-Xmas tree
http://www.microbialart.com/wp-content/uploads/bfi_thumb/08-Xmas-tree-31mp03jls8xod4r0vezeve.jpg
-
08-Sunflower2
http://www.microbialart.com/wp-content/uploads/bfi_thumb/08-Sunflower2-31mp03619dc40zieptfg22.jpg
-
07-lily
http://www.microbialart.com/wp-content/uploads/bfi_thumb/07-lily-31mp02nxw77cwsix6cotmy.jpg
-
06-Thistle
http://www.microbialart.com/wp-content/uploads/bfi_thumb/06-Thistle-31mp02addblsknab0r4utm.jpg
-
05-sun
http://www.microbialart.com/wp-content/uploads/bfi_thumb/05-sun-31mp025uj12lsljfmvy77u.jpg
-
05-Rose
http://www.microbialart.com/wp-content/uploads/bfi_thumb/05-Rose-31mp01wsug088i1ov5kw0a.jpg
-
04-trag_com2
http://www.microbialart.com/wp-content/uploads/bfi_thumb/04-trag_com2-31mp01j8bkenwct2pk0x6y.jpg
-
03-trag_com1
http://www.microbialart.com/wp-content/uploads/bfi_thumb/03-trag_com1-31mp0114ye9ws5tl63aaru.jpg
-
03-Butterfly
http://www.microbialart.com/wp-content/uploads/bfi_thumb/03-Butterfly-31mp00j1l855nyu3mmjocq.jpg
-
02-Plate streaking
http://www.microbialart.com/wp-content/uploads/bfi_thumb/02-Plate-streaking-31mp009zwn2s3vccuw6d56.jpg
-
02-appletree
http://www.microbialart.com/wp-content/uploads/bfi_thumb/02-appletree-31mozzwfdrh7rq3qpamebu.jpg
-
01-pink ele
http://www.microbialart.com/wp-content/uploads/bfi_thumb/01-pink-ele-31mozzndp6eu7mlzxk934a.jpg


